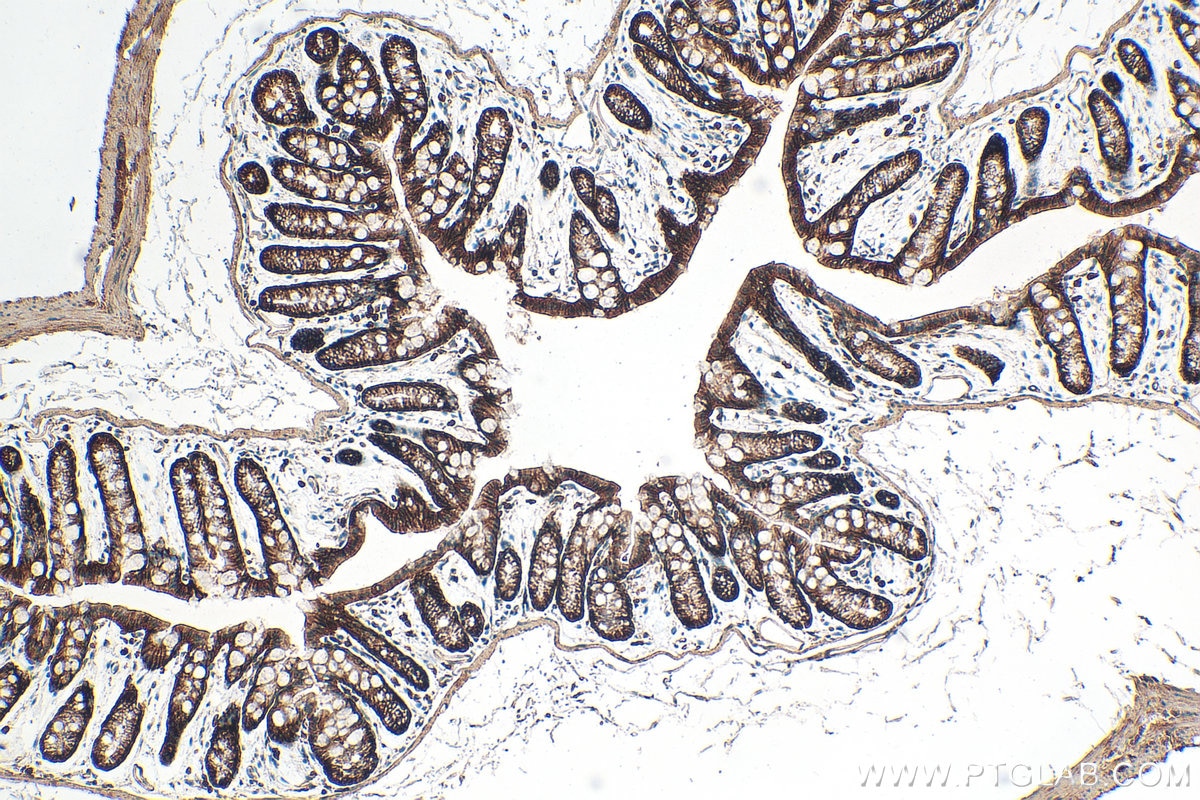
Immunohistochemistry (IHC) staining of mouse colon tissue using Integrin Alpha 3 Polyclonal antibody (21992-1-AP)
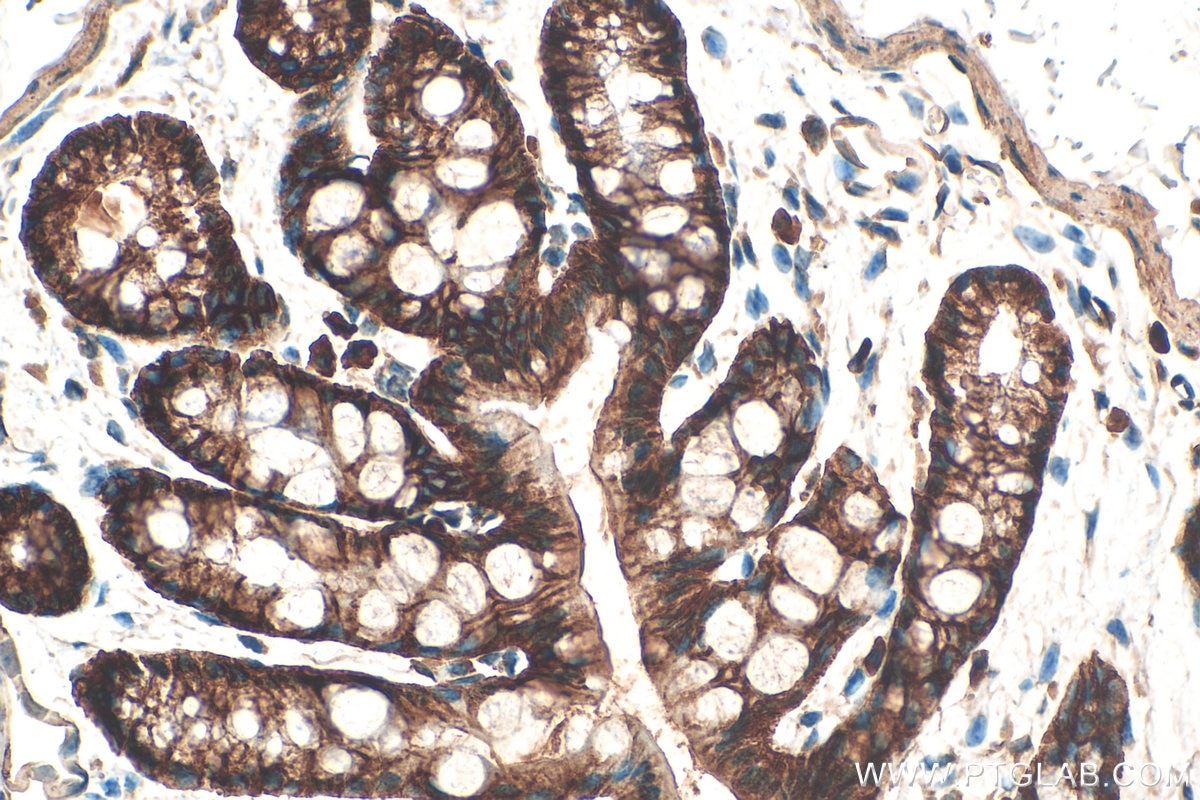
Immunohistochemistry (IHC) staining of mouse colon tissue using Integrin Alpha 3 Polyclonal antibody (21992-1-AP)

Tested Applications
| Positive WB detected in | A549 cells, human heart tissue, human testis tissue, Calu-1 cells, PC-3 cells |
| Positive IP detected in | PC-3 cells |
| Positive IHC detected in | mouse colon tissue Note: suggested antigen retrieval with TE buffer pH 9.0; (*) Alternatively, antigen retrieval may be performed with citrate buffer pH 6.0 |
| Positive IF/ICC detected in | A549 cells |
Recommended dilution
| Application | Dilution |
|---|---|
| Western Blot (WB) | WB : 1:5000-1:50000 |
| Immunoprecipitation (IP) | IP : 0.5-4.0 ug for 1.0-3.0 mg of total protein lysate |
| Immunohistochemistry (IHC) | IHC : 1:500-1:2000 |
| Immunofluorescence (IF)/ICC | IF/ICC : 1:200-1:800 |
| It is recommended that this reagent should be titrated in each testing system to obtain optimal results. | |
| Sample-dependent, Check data in validation data gallery. | |
Published Applications
| KD/KO | See 1 publications below |
| WB | See 9 publications below |
| IHC | See 2 publications below |
| IF | See 5 publications below |
| IP | See 1 publications below |
| CoIP | See 1 publications below |
Product Information
21992-1-AP targets Integrin Alpha 3 in WB, IHC, IF/ICC, IP, CoIP, ELISA applications and shows reactivity with human, mouse samples.
| Tested Reactivity | human, mouse |
| Cited Reactivity | human, mouse |
| Host / Isotype | Rabbit / IgG |
| Class | Polyclonal |
| Type | Antibody |
| Immunogen |
CatNo: Ag17293 Product name: Recombinant human Integrin alpha-3 protein Source: e coli.-derived, PGEX-4T Tag: GST Domain: 52-376 aa of BC150190 Sequence: FGYSVALHRQTERQQRYLLLAGAPRELAVPDGYTNRTGAVYLCPLTAHKDDCERMNITVKNDPGHHIIEDMWLGVTVASQGPAGRVLVCAHRYTQVLWSGSEDQRRMVGKCYVRGNDLELDSSDDWQTYHNEMCNSNTDYLETGMCQLGTSGGFTQNTVYFGAPGAYNWKGNSYMIQRKEWDLSEYSYKDPEDQGNLYIGYTMQVGSFILHPKNITIVTGAPRHRHMGAVFLLSQEAGGDLRRRQVLEGSQVGAYFGSAIALADLNNDGWQDLLVGAPYYFERKEEVGGAIYVFMNQAGTSFPAHPSLLLHGPSGSAFGLSVASI Predict reactive species |
| Full Name | integrin, alpha 3 (antigen CD49C, alpha 3 subunit of VLA-3 receptor) |
| Calculated Molecular Weight | 1066 aa, 119 kDa |
| Observed Molecular Weight | 130-140 kDa |
| GenBank Accession Number | BC150190 |
| Gene Symbol | Integrin alpha 3 |
| Gene ID (NCBI) | 3675 |
| RRID | AB_10953527 |
| Conjugate | Unconjugated |
| Form | Liquid |
| Purification Method | Antigen affinity purification |
| UNIPROT ID | P26006 |
| Storage Buffer | PBS with 0.02% sodium azide and 50% glycerol, pH 7.3. |
| Storage Conditions | Store at -20°C. Stable for one year after shipment. Aliquoting is unnecessary for -20oC storage. 20ul sizes contain 0.1% BSA. |
Background Information
ITGA3, also named as MSK18, CD49c, GAPB3 and FRP-2, belongs to the integrin alpha chain family. It is a receptor for fibronectin, laminin, collagen, epiligrin, thrombospondin and CSPG4. ITGA3 may mediate with LGALS3 the stimulation by CSPG4 of endothelial cells migration. ITGA3 is highly concentrated in epithelial cells where it strongly adheres to Laminin-5 and Laminin-5 induced rapid adhesion can be blocked by antibodies against the alpha-3 integrin subunit. It can be cleaved into heavy chain(840aa) and light chain(176aa). This antibody can recognize the heavy chain.
Protocols
| Product Specific Protocols | |
|---|---|
| IF protocol for Integrin Alpha 3 antibody 21992-1-AP | Download protocol |
| IHC protocol for Integrin Alpha 3 antibody 21992-1-AP | Download protocol |
| IP protocol for Integrin Alpha 3 antibody 21992-1-AP | Download protocol |
| WB protocol for Integrin Alpha 3 antibody 21992-1-AP | Download protocol |
| Standard Protocols | |
|---|---|
| Click here to view our Standard Protocols |
Publications
| Species | Application | Title |
|---|---|---|
J Adv Res OTUD1 delays wound healing by regulating endothelial function and angiogenesis in diabetic mice | ||
Front Oncol High Expression of Integrin α3 Predicts Poor Prognosis and Promotes Tumor Metastasis and Angiogenesis by Activating the c-Src/Extracellular Signal-Regulated Protein Kinase/Focal Adhesion Kinase Signaling Pathway in Cervical Cancer. | ||
Int J Mol Med miR-1307-3p suppresses the chondrogenic differentiation of human adipose-derived stem cells by targeting BMPR2. | ||
Sci Rep Elevated ITGA3 expression serves as a novel prognostic biomarker and regulates tumor progression in cervical cancer | ||
Acta Biochim Biophys Sin (Shanghai) Exosomal integrin alpha 3 promotes epithelial ovarian cancer cell migration via the S100A7/p-ERK signaling pathway | ||
Biochim Biophys Acta Mol Basis Dis KBU2046 exerts inhibition on chemokine gradient-mediated motility of esophageal squamous cell carcinoma through reducing integrin expression |